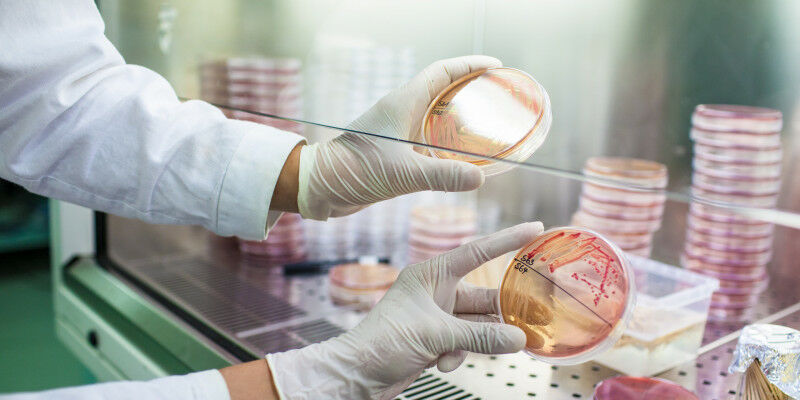

Ein balancierte biologische Vielfalt wäre eine natürliche ’Versicherung’ gegen Pandemien.
Ein balancierte biologische Vielfalt wäre eine natürliche ’Versicherung’ gegen Pandemien.
Ein balancierte biologische Vielfalt wäre eine natürliche 'Versicherung' gegen Pandemien. Lukas Grumet - Das Coronavirus hält die Welt in Atem. Welche Rolle das Mikrobiom für diese und andere Pandemien spielt, erklärt Umweltbiotechnologin Gabriele Berg, die Leiterin des Instituts für Umweltbiotechnologie an der TU Graz. Das Mikrobiom setzt sich aus der Mikrobiota und ihrem umgebenden Lebensraum zusammen. Alle lebenden Mikroorganismen, Bakterien, Archeen (Urbakterien), Pilze, Algen und Protisten - eine bestimmte Gruppe einbis mehrzelliger Lebewesen - bilden die Mikrobiota, während die Viren nicht darin leben, aber dem umgebenden Lebensraum angehören. Ein gesundes Mikrobiom ist divers, gleichmäßig strukturiert und bildet ein ausbalanciertes funktionelles Netzwerk. Darin sind auch viele potenzielle Krankheitserreger enthalten, die hier wichtige Funktionen erfüllen: Viren sind beispielsweise wichtige Dirigenten der Evolution und der Koexistenz.
TO READ THIS ARTICLE, CREATE YOUR ACCOUNT
And extend your reading, free of charge and with no commitment.
Your Benefits
- Access to all content
- Receive newsmails for news and jobs
- Post ads